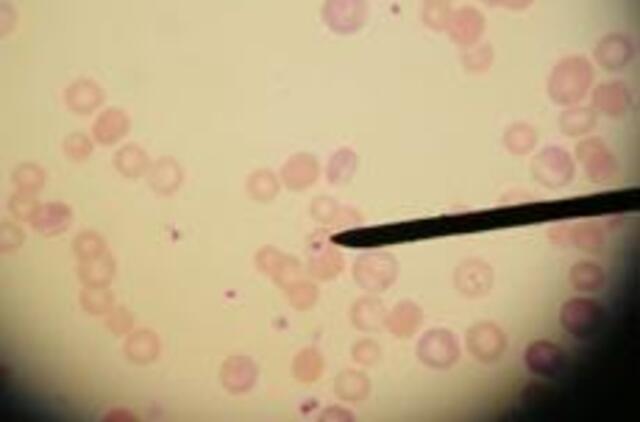
Kazachstane nuo juodligės mirė 38 metų vyras

Pietinėje Kazachstano dalyje nuo juodligės mirė 38 metų vyras, ketvirtadienį pranešė šalies Nepaprastųjų padėčių ministerijos atstovas. Vyras buvo atvežtas į Lengero miesto ligoninę pirmadienį, kur buvo gydomas intensyvios priežiūros skyriuje. Ministerijos atstovo teigimu, vyras užsikrėtė skersdamas galviją.
Šioje Vidurio Azijos valstybėje juodligės protrūkiai yra gana dažni. Gaunama informacijos, kad sergančių galvijų savininkai išvengdami veterinarijos patikrinimų parduoda infekuotų galvijų mėsą.
Juodligė yra labai pavojinga mirtina liga, tačiau kai kurių formų ligą pavyksta išgydyti antibiotikais.
Eltos inf.

Rašyti komentarą